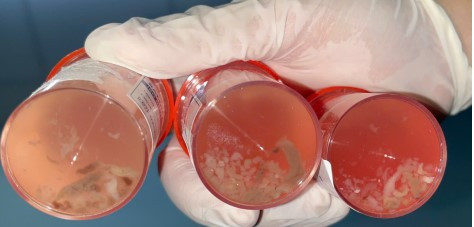
“Dị vật” màu trắng xám (giun lươn) từ dịch rửa phế quản phổi người bệnh. Ảnh BVCC

Mới đây, theo thông tin từ Bệnh viện Nhân Dân 115, bệnh nhân nữ 64 tuổi (Tiền Giang), có tiền căn bệnh đau xương khớp, tăng huyết áp, suy thượng thận, nhập viện vì khó thở và ho.
Khi thăm khám các bác sĩ ghi nhận bệnh nhân trong 1 tháng nay có biểu hiện ăn kém, sụt cân, ho và khó thở, điều trị tại địa phương không thuyên giảm
Các xét nghiệm cho thấy bệnh nhân có tình trạng thiếu máu mức độ trung bình, tăng bạch cầu ái toan (một trong những chỉ điểm của tình trạng nhiễm ký sinh trùng), viêm phổi với tổn thương dạng nốt lan tỏa hai phổi.
![]() |
| “Dị vật” màu trắng xám (giun lươn) từ dịch rửa phế quản phổi người bệnh. Ảnh BVCC |
Bệnh nhân được chỉ định nội soi phế quản và nội soi dạ dày tá tràng để kiểm tra, ghi nhận tình trạng viêm dạ dày tá tràng có nhiều chấm trắng li ti gợi ý tình trạng nhiễm ký sinh trùng.
Khi các bác sĩ tiến hành nội soi phế quản cho bệnh nhân, bơm rửa ghi nhận được nhiều dị vật màu trắng xám, kiểm tra dưới kính hiển vi ghi nhận là ấu trùng giun lươn. Từ đó chẩn đoán của bệnh nhân được xác định là một tình trạng nhiễm giun lươn nặng ở phổi và ruột trên cơ địa suy giảm miễn dịch. Bệnh nhân được điều trị với thuốc đặc hiệu và xuất viện sau đó.
Trường hợp thứ hai là người đàn ông 69 tuổi (Tiền Giang), có tiền sử ung thư thanh quản, nhập viện tại Bệnh viện Nhân dân 115 do ăn kém, nôn ói, đau bụng, ho và khó thở kéo dài 10 ngày.
Tại khoa Hô hấp - Hồi sức tim mạch, kết quả chụp cắt lớp vi tính ngực và ổ bụng cho thấy hẹp môn vị nghi do ký sinh trùng và tổn thương phổi hoại tử hai bên. Xét nghiệm dịch rửa phế quản phát hiện ký sinh trùng, bệnh nhân được chẩn đoán nhiễm giun lươn nặng ở phổi và điều trị đặc hiệu theo phác đồ.
![]() |
| Tổn thương phổi hoại tử hai bên của người bệnh. Ảnh BVCC |
Qua hai ca bệnh trên, có thể thấy nhiễm giun lươn tuy là một bệnh thường gặp, có thể xảy ra trên nhiều hệ cơ quan khác nhau, diễn biến bất thường và nặng nề, đặc biệt ở những người bệnh có hệ miễn dịch suy yếu, từ đó có thể thấy dự phòng và phát hiện, điều trị sớm bệnh rất quan trọng.
Nhiễm giun lươn là gì?
ThS.BS Đặng Nam Hải - Khoa Hô hấp - Hồi sức tim mạch cho biết, giun lươn với tên khoa học là Strongyloides spp., trong đó loài hay gây bệnh ở người là Strongyloide stercoralis. Nhiễm giun lươn là tình trạng nhiễm ký sinh trùng thường gặp ở vùng nhiệt đới và cận nhiệt đới như Việt Nam. Khoảng 100 - 370 triệu người trên thế giới bị nhiễm, và tại Việt Nam, tỷ lệ nhiễm có thể lên đến 20%.
Người bệnh có thể bị nhiễm khi tiếp xúc với ấu trùng giun lươn trong đất hoặc khi trứng giun nở trong ruột và tự sinh sôi. Ấu trùng giun lươn không chỉ gây bệnh ở đường tiêu hóa mà còn có thể xâm nhập vào phổi và các cơ quan khác, dẫn đến những biến chứng nguy hiểm, thậm chí đe dọa tính mạng.
Làm sao để phòng tránh nhiễm giun lươn?
- Giữ vệ sinh cá nhân: rửa tay bằng xà phòng.
- Ăn chín uống sôi, tránh thức ăn sống, tái.
- Dùng giày dép khi tiếp xúc đất, cát.
- Khám sàng lọc nếu có triệu chứng nghi ngờ.
Triệu chứng gợi ý có thể nhiễm giun lươn
- Rối loạn tiêu hóa: đau bụng, nôn, biếng ăn, sụt cân.
- Biểu hiện ngoài da: ngứa, phát ban.
- Biến chứng nặng: viêm phổi, suy hô hấp, viêm não màng não, suy gan, suy thận.
- Đối với người suy giảm miễn dịch, bệnh có thể trở nên nguy kịch